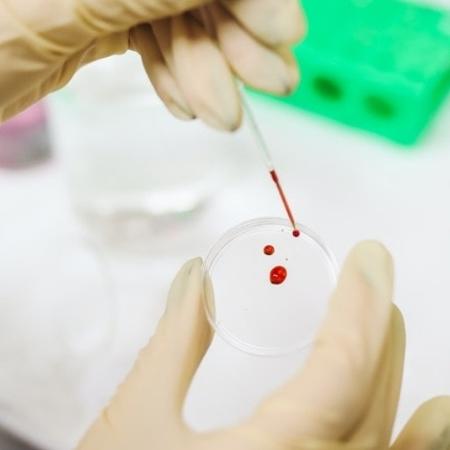

HIV/Aids no Brasil: há crescimento entre homens, mas redução entre mulheres
Historicamente, a proporção de casos de HIV entre homens sempre foi maior do que entre as mulheres. Os dados mais recentes do Boletim Epidemiológico HIV/Aids, divulgado no início de dezembro, não apenas reforçam essa estatística, mas também surpreendem pelo aumento na última década.
Entre 15 e 19 anos de idade, os jovens tiveram um aumento de 29% no número de casos. Na faixa etária seguinte, dos 20 aos 24 anos, o crescimento foi de 20,2%. No caso das mulheres, no mesmo período, foram registradas quedas em todas as faixas etárias. A mais expressiva foi entre os 30 e 34 anos, com uma redução de 61,1%.
Em 2007, por exemplo, para cada 10 mulheres diagnosticadas com o vírus havia 14 homens na mesma condição. Em 2020, para cada 10 mulheres, 28 casos eram em homens. O relatório destaca que, entre as mulheres, a redução na última década chegou a 50%, passando de 16 casos por 100 mil habitantes em 2010 para apenas oito casos/100 mil, em 2020.
Na avaliação do infectologista Fernando Vieira de Souza, do Instituto de Infectologia Emílio Ribas, os dados demonstram que as mulheres estão se cuidando mais, enquanto os homens continuam se expondo ao risco, sem tomar as medidas de prevenção.
“Uma das hipóteses é que esse homem jovem não se preocupa com a doença porque ele sabe que existe tratamento. Mas, apesar de os medicamentos estarem disponíveis para todos, nem todo mundo consegue tomar essas drogas, pois além de casos de intolerância, há risco de outros efeitos adversos, como lesão renal ou hepática em decorrência do uso prolongado”, alerta.
Segundo Souza, algo impactou a queda acentuada de casos entre as mulheres de todas as faixas etárias e o que tiver dado certo deve ser replicado entre os homens. “Se houve essa redução entre as mulheres, por que não conseguimos atingir os homens? Esse relatório é fundamental para que o governo estude esses casos e chegue a um entendimento para que possa direcionar as políticas de saúde pública adequadamente para os homens jovens”, avalia Souza, que ressalta que a adesão ao tratamento é muito mais alta em mulheres.
Média anual
Apesar de a média anual, nos últimos cinco anos, ser de 36,8 mil novos casos de HIV, houve uma queda em 2020, em comparação com o ano anterior. Foram 29.197 registros em 2020 contra 37.731, em 2019 – uma redução de 20,7%.
Na opinião de Souza, esse dado ainda não pode ser comemorado devido a um possível impacto da pandemia da covid-19. “As pessoas também saíram menos de casa durante o isolamento social e se expuseram menos. Temos de esperar mais alguns anos para ver se essa queda se mantém dessa forma”, pondera o infectologista. No mesmo período, o número de mortes caiu apenas 2,52% (10.417 mortes em 2020 contra 10.687 em 2019).
Prevenção
No Dia Mundial de Luta contra o HIV, lembrado todo 1º de dezembro, o Ministério da Saúde lançou a campanha “Prevenir é sempre a melhor escolha” para conscientizar os brasileiros sobre a importância do cuidado contra o vírus. A pasta informou ainda que distribuiu 20,8 milhões de testes rápidos para diagnóstico nos anos de 2020 e 2021, sendo que foram 12 milhões apenas neste ano. Cerca de 370 milhões de preservativos também foram enviados para todos os estados.
O infectologista Souza reforça que o diagnóstico precoce é fundamental e que o país precisa investir nas estratégias de tratamento via PREP (profilaxia pré-exposição, recomendada especialmente para profissionais do sexo) quanto via PEP (profilaxia pós-exposição, indicada para casos de violência sexual, por exemplo). “Precisamos ampliar o acesso ao diagnóstico precoce e continuar atuando nas duas frentes de ação de tratamento. Só dessa maneira vamos conseguir quebrar a cadeia de transmissão da doença”, finalizou.
Fonte: UOL